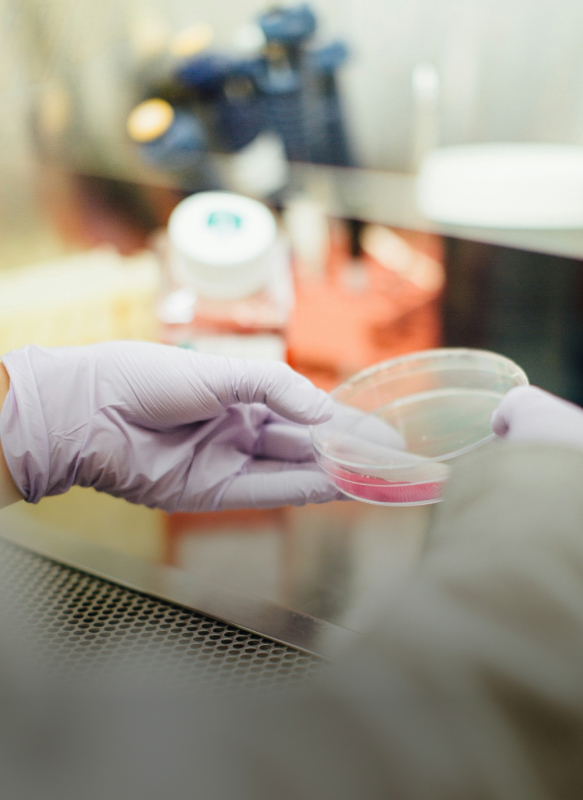
Celiachia

Custodiamo la salute con tradizione
Farmacie Pisano & Gutierrez
La Farmacia Manlio Pisano, la più antica Farmacia fondata a Sassari nel marzo del 1868, e la Farmacia Gutierrez aperta dal Febbraio del 1898 sono oggi liete di annunciare ai loro pazienti l'unione di professionalità accademica e umana sotto un unico nome.
Servizi
Nelle nostre farmacie troverete prodotti e servizi di qualità per ogni necessità in grado di soddisfare ogni vostra esigenza.
Il nostro staff vi seguirà attentamente per ogni richiesta!
scopri

Laboratorio Galenico
L'incontro tra tradizione e continua innovazione rende possibile la preparazione di farmaci completamente
personalizzabili così da garantire i migliori risultati terapeutici.
I nostri Brand

Fidelity Card

Richiedi la Fidelity Card
Accedi a sconti e servizi esclusivi con la fidelity card delle Farmacie Pisano Gutierrez
scopriOrari
Farmacia Manlio Pisano
Via Brigata Sassari, 15 - 07100 Sassari Tutti i giorni dal Lunedì al Sabato dalle 09:00 alle 13:00 e dalle 16:30 alle 20:00Domenica Chiuso
Farmacia Gutierrez
Via Roma, 16 - 07100 Sassari Tutti i giorni dal Lunedì al Venerdì dalle 09:00 alle 13:00 e dalle 16:30 alle 20:00Sabato dalle 09:00 alle 13:00
Domenica Chiuso